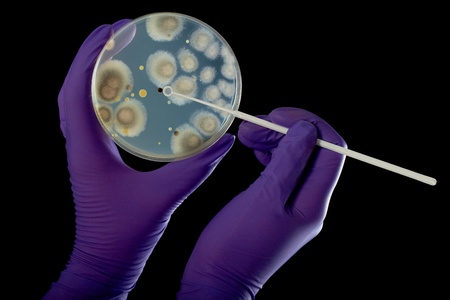
hand in violet glove holds petri dish with bacterium, isolated on blackの写真素材

写真素材 - hand in violet glove holds petri dish with bacterium, isolated on black
作品情報
hand in violet glove holds petri dish with bacterium, isolated on black
- ID:11615554
- 作品種別:写真
- 作者名:miszaqq
キーワード
- analysis
- analyzing
- bacteria
- bacterium
- biological
- biology
- biotechnology
- black
- cells
- colonies
- culture
- dirt
- disease
- dish
- experiment
- fungi
- germs
- glove
- growth
- hand
- health
- healthcare
- holding
- hygiene
- infection
- instrument
- isolated
- jelly
- lab
- laboratory
- media
- medical
- medicine
- microbiology
- organism
- petri
- plate
- poisonous
- protective
- purple
- research
- sample
- science
- scientific
- sickness
- technology
- violet
- virus
- yellow
- agar
類似作品
Cozy pink texti...
Professional eq...
The shadow of t...
Purple Rubber g...
Plants seed stu...
A female hand i...
Purple human pa...
Hand makes the ...
Man Holding Mob...
Female hand in ...
Closeup of tatt...
Hand holding a ...
Purple cleaning...
Thumb down in l...
Close up of fem...
Man Holding Mob...
Close up of Hum...
pink gloves in ...
hand in surgica...
Hand in a pop a...
Hand in glove h...
Colorful surgic...
Purple female h...
Little girl pla...
Male finger poi...
Textured USA fl...
Mummy's hand wr...
Employee hand i...
wear beautiful ...
Five counting r...
closeup of the ...
closeup of the ...
Hand Of Female ...
Hands in rubber...
Hand in rubber ...
cropped image o...
Person's hand r...
Symptoms of art...
3d render, funn...
Hand symbol, sa...
gloved hand wit...
Female hands dy...
Rubber glove on...
Hand in rubber ...
Hand In Medical...
closeup of the ...
Hand in rubber ...
The doctor puts...
Hand in a pop a...